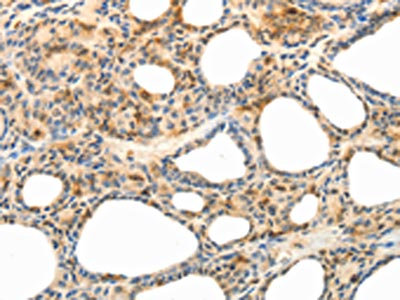

CCR8 Antibody
-
中文名稱:CCR8兔多克隆抗體
-
貨號:CSB-PA172806
-
規格:¥1100
-
圖片:
-
The image on the left is immunohistochemistry of paraffin-embedded Human thyroid cancer tissue using CSB-PA172806(CCR8 Antibody) at dilution 1/40, on the right is treated with synthetic peptide. (Original magnification: ×200)
-
Gel: 10%SDS-PAGE, Lysate: 80 μg, Lane 1-2: Hela cells, K562 cells, Primary antibody: CSB-PA172806(CCR8 Antibody) at dilution 1/200, Secondary antibody: Goat anti rabbit IgG at 1/8000 dilution, Exposure time: 30 seconds
-
-
其他:
產品詳情
-
Uniprot No.:
-
基因名:
-
別名:CCR8; CKRL1; CMKBR8; CMKBRL2; C-C chemokine receptor type 8; C-C CKR-8; CC-CKR-8; CCR-8; CC chemokine receptor CHEMR1; Chemokine receptor-like 1; CKR-L1; GPR-CY6; GPRCY6; TER1; CD antigen CDw198
-
宿主:Rabbit
-
反應種屬:Human
-
免疫原:Synthetic peptide of Human CCR8
-
免疫原種屬:Homo sapiens (Human)
-
標記方式:Non-conjugated
-
抗體亞型:IgG
-
純化方式:Antigen affinity purification
-
濃度:It differs from different batches. Please contact us to confirm it.
-
保存緩沖液:-20°C, pH7.4 PBS, 0.05% NaN3, 40% Glycerol
-
產品提供形式:Liquid
-
應用范圍:ELISA,WB,IHC
-
推薦稀釋比:
Application Recommended Dilution ELISA 1:1000-1:5000 WB 1:200-1:1000 IHC 1:25-1:100 -
Protocols:
-
儲存條件:Upon receipt, store at -20°C or -80°C. Avoid repeated freeze.
-
貨期:Basically, we can dispatch the products out in 1-3 working days after receiving your orders. Delivery time maybe differs from different purchasing way or location, please kindly consult your local distributors for specific delivery time.
-
用途:For Research Use Only. Not for use in diagnostic or therapeutic procedures.
相關產品
靶點詳情
-
功能:Receptor for the chemokine CCL1/SCYA1/I-309. May regulate monocyte chemotaxis and thymic cell line apoptosis. Alternative coreceptor with CD4 for HIV-1 infection.
-
基因功能參考文獻:
- Authors demonstrate the pivotal role of CCR8(+) Treg cells in restraining immunity and highlight the potential clinical implications of this discovery. PMID: 28533380
- Role of Conserved Disulfide Bridges and Aromatic Residues in Extracellular Loop 2 of Chemokine Receptor CCR8 for Chemokine and Small Molecule Binding. PMID: 27226537
- High CCR8 expression is associated with high recurrence in kidney cancer. PMID: 26716905
- findings suggest that CCR8 expression in ALCL is more closely related to the presence of DUSP22 rearrangements than to cutaneous involvement and that the function of CCR8 may extend beyond its skin-homing properties in this disease PMID: 25390351
- Epidermal-derived vitamin D3 metabolites and prostaglandins provide an essential cue for the localization of CCR8+ immune surveillance T cells within healthy human skin. PMID: 26002980
- CCL1-CCR8 interaction may play a critical role in lymphocytic recruitment in IgG4-related sclerosing cholangitis and type 1 autoimmune pancreatitis, leading to duct-centred inflammation and obliterative phlebitis. PMID: 23811304
- Identification of human CCR8 as a CCL18 receptor. PMID: 23999500
- CCR8(+) myeloid cell subset is expanded in patients with cancer. PMID: 23363815
- Data show that CCR8 expression by newly activated naive T cells is regulated by skin-specific factor(s) derived primarily from epidermal keratinocytes. PMID: 23043070
- C-terminal clipping of chemokine CCL1/I-309 enhances CCR8-mediated intracellular calcium release and anti-apoptotic activity PMID: 22479563
- The functional data from human macrophages suggest a potential cross talk between the CCR8 and the Toll-like receptor 4 (TLR4) pathways, both of which are present in chronic obstructive pulmonary disease patients. PMID: 21976223
- There may be a role for CCR8 in the recruitment of T cells to the lung in asthmatics. PMID: 20455898
- CCR8 mediates rescue from dexamethasone-induced apoptosis via an ERK-dependent pathway PMID: 12525579
- found in the central nervous system and is associated with phagocytic macrophages PMID: 12547701
- CCR8 genes and surrounding genomic regions these genes are the result of the duplication of an ancestral gene prior to the divergence of teleost fish. PMID: 12551893
- Transfected human CCR8-dependent activation of the RAS/MAPK pathway mediates anti-apoptotic activity of I-309/ CCL1 and vMIP-I. PMID: 12645948
- The induction of CCR8 under conditions associated with vascular smooth muscle cell proliferation and migration raises the possibility that CCR8 may play an important role in vessel wall pathology. PMID: 14576057
- the axis CCL1-CCR8 links adaptive and innate immune functions that play a role in the initiation and amplification of atopic skin inflammation PMID: 15814739
- CCR8 ligands are allotropic, binding to distinct sites within CCR8; the human immune system may have evolved to use CCL7 as a selective antagonist of viral chemokine activity at CCR8 but not those of the host ligand PMID: 17023422
- CCR8 is expressed by a small and heterogeneous population of peripheral blood CD4 memory T cells enriched in T helper type 2 (Th2) effector and T regulatory (Treg) cells. PMID: 17082609
- CCR8-expressing CD4-positive T lymphocytes are preferentially recruited from the periphery into the lungs of asthmatic individuals, driven by elevated CCL1 levels produced almost exclusively by mast cells and basophils. PMID: 17641040
- The combination of 17beta-E(2) with the environmental pollutant TCDD is involved in the pathogenesis of endometriosis via up-regulating the chemokine CCR8-I-309. PMID: 17693327
顯示更多
收起更多
-
亞細胞定位:Cell membrane; Multi-pass membrane protein.
-
蛋白家族:G-protein coupled receptor 1 family
-
數據庫鏈接:
Most popular with customers
-
-
YWHAB Recombinant Monoclonal Antibody
Applications: ELISA, WB, IHC, IF, FC
Species Reactivity: Human, Mouse, Rat
-
-
-
-
-
VCP Recombinant Monoclonal Antibody
Applications: ELISA, WB, IHC, IF, IP
Species Reactivity: Human, Rat
-